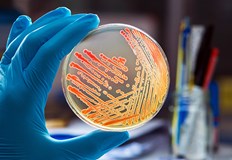
Той се е заразил след като се е измил с

... телефонните обаждания.“Кадри показват пристигащи и заминаващи линейки, а някои туристи са били поставени на системи за рехидратация в стаите си или на носилки в коридорите.
Заразяване След - Новини
Дете в Ливърпул е починало след договаряне на морбили съобщава
...... трудности при резервацията и посещаването на срещи и липса на приемственост на грижите, като много родители виждат различен личен лекар или клиницист при всяко посещение.
11 месечно бебе е починало след заразяване с в столицата За
...... се направи проверка и на място в болницата. За още новини вижте Присъединете се към нашия Директор от София: Учениците крият втори телефон, време е за строги мерки
Млад мъж е в сериозно състояние след прекаран енцефалит заради
...... карта, PayPal, ApplePay, GooglePay, Revolut или по IBAN сметка:Банка: Алианц Банк БългарияIBAN: BG97BUIN95611000740294BIC: BUINBGSFПолучател: Фондация Павел АндреевОснование: Станимир Павлов ДелчевКакто и на платфомата Павел Андреев
Здравните служители на Ню Хемпшир казаха във вторник че човек
...... Уолъс е репортер за извънредни новини и политика във Fox News Digital. Съвети за истории могат да се изпращат на [email protected] и на X: @danimwallace.
Мъж почина от заболяване подобно на Ебола наречено Кримско Конго хеморагична
...... ще видим повече случаи през следващите години“, каза Томсън пред CNN в понеделник. „Съществува риск от разпространение и в други европейски страни, включително Обединеното кралство.“
Опозореният и затворен филмов магнат Харви Уайнстийн показа положителен тест
...... нападение в Лос Анджелис. По това дело Уайнщайн беше осъден на 16 години затвор. Той твърди, че е невинен и отрича всякакви сексуални действия без съгласие.
Здравните власти в Израел заявиха че може би са открили
...... естествени водни басейни при температура на водата 25-30 градуса по Целзий. Амебата може да навлезе в човешкия организъм през носа, след което навлиза в мозъка.
Млад мъж в Израел почина от енцефалит след като се
...... на водата с амеба.Naegleria fowleri живее в сладки водоеми; амебата може да влезе в човешкото тяло през носните проходи, след което паразитът навлиза в мозъка.
ЮГИЙН Орегон AP — Спринтьорът Ерийон Найтън даде положителен тест
...... от бурито, което е купила и съдържа месо, подправено с нандролон.Houlihan в момента изтърпява четиригодишна забрана, която изтича следващата година.___Летни олимпийски игри на AP: https://apnews.com/hub/2024-paris-olympic-games
Доктор се сблъска с трудна ситуация когато остана парализиран дни
...... и по-добро разбиране на опита на пациента“, каза той, „Надявам се, че мога да осигуря същото състрадание и подкрепа на други хора в подобни ситуации.“
Ухапванията от дървеници могат лесно да бъдат забелязани ако познавате
...... заразата се е разпространила в други части на сградата, включително 10-ия етаж, който се използва от Агенцията за регулиране на лекарствата и здравните продукти (MHRA).
Той каза на своите избиратели през декември че е бил
...... център на парламента, искам те да бъдат дърпайки сакото или полите на родителите си или учителя си и казвайки: „Искам да видя бионичния депутат днес“.
Следовател от щатската полиция на Вирджиния остана объркан от твърденията
...... му твърдят, че това го е направило мишена за малтретиране. През юли беше съобщено, че ФБР разследва смъртта му. Гражданският процес е насрочен за януари.
Новородено бебе беше принудено да прекара 10 дни в кома
...... заболяването. Кери добави: „Трябва да образоваме хората относно ваксината и симптомите. Коклюшът е опасен за новородените и искам хората да знаят за какво да внимават.“
Ник Джонас обяви че няколко концерта от текущото турне на
...... на 22 февруари. The Jonas Brothers са в момента планират да завършат световното си турне с шоу в Tauron Arena Kraków в Полша на 16 октомври.
Вкрая на седмицата стана ясно че две бебета са починали след заболяване
...... ваксиниран човек да има тази бактерия, но да няма симптоми и да предаде заболяването на друг", каза лекаря. Не пропускайте най-важните новини - последвайте ни в
Министерство на здравеопазването потвърди че са регистрирани два смъртни случая
...... е било по-неефективно", обясни главнаят държавен инспектор. Ваксини се поставят на деца на 2, 3 и 4 месеца. След това на 5, 6 и 12-годишна възраст.
Две бебета от Кюстендил са починали след заразяване с коклюш
...... които не са получили първата си ваксина. Сред най-разпознаваемите симптоми са повишаване на температурата и пристъпи на остра и продължителна кашлица, които не могат да бъдат облекчени.БНР
Децата са от Кюстендил били са в предимунизационна възраст не
...... 3 и 4 доза на възраст от 11-24 месеца, и още една - между 3 и 7 години. Последната имунизация срещу болестта е на 12-годишна възраст.
Ситуацията с разпространението на коклюш у нас продължава да се
...... ваксина. Сред най-разпознаваемите симптоми са кихане, леко повишаване на температурата и пристъпи на кашлица, които не могат да бъдат облекчени. Кашлицата винаги е остра и продължителна.
Децата са били в предимунизационна възраст уточни той За връщането на
...... 3 и 4 доза на възраст от 11-24 месеца, и още една - между 3 и 7 години. Последната имунизация срещу болестта е на 12-годишна възраст.
Две бебета от Кюстендил са починали след заразяване с коклюш
...... които не са получили първата си ваксина. Сред най-разпознаваемите симптоми са повишаване на температурата и пристъпи на остра и продължителна кашлица, които не могат да бъдат облекчени.
Първи смъртни случаи след заболяване с коклюш у нас от
...... на малките бебета се предлагат три дози от лекарството против коклюш на 8, 12 и 16 седмици.По тематаНе пропускайте най-важните новини - последвайте ни в
Първи смъртни случаи на коклюш са регистрирани у нас за
...... заразили и не са могли да преборят болестта. Това съобщи държавният здравен инспектор доц. Ангел Кунчев, цитиран от Нова телевизия. Бебетата са били в предимунизационна възраст, допълни Кунчев.
Лесли Аш е живяла две десетилетия с придобита в болница
...... пиесата на Арън Такър Artificially Yours, с участието на Тайгър Дрю-Хъни (Outnumbered, Cuckoo)... и Лесли Аш в главната роля на Пипа. Следвайте Mirror Celebs на,и.
На седемгодишно момиче бяха ампутирани няколко крайника през последните две
...... пациентът да отиде при болницата." Сепсисът често води до органна недостатъчност, както в случая на Виктория. Всяка година в САЩ 1,7 милиона души развиват сепсис.
Професионалист в Strictly Come Dancing балната танцьорка Ейми Доудън разкри
...... не я отлагайте, просто я направете.“Ейми Доудън сподели историята си в подкаста Crisis What Crisis, водещ от Andy Coulson. За да слушате подкаста, щракнете тук
Медицинските експерти тази седмица публикуваха изобличителен доклад от аутопсията разкриващ
...... инвазивен Streptococcus pyogenes, известен също като стрептокок от група А, който бързо става фатален.Сепсисът може да доведе до сериозни усложнения само за 24 часа. "
Възрастен който се е заразил с морбили е починал в
...... увеличават в Англия.Миналата седмица Агенцията за здравна сигурност на Обединеното кралство (UKHSA) заяви, че продължаващото огнище на морбили в Уест Мидландс "остава повод за безпокойство".
Трини Удол каза че се чувства така сякаш побърква
...... Лили и лурчер Дафи.Тя се раздели с рекламния гуру Чарлз Саачи миналата година и сега споделя дома си с доведения си син и племенника си.
Японската престолонаследница Кико Съобщава се че е преминала допълнителен медицински
...... удариха пристанище Wajima в префектура Ishikawa в 16:21 ч. местно време точно когато тъмнината падна в региона, като много повече се очакват през следващите дни.
Известният радиоводещ Хауърд Стърн който от години изразява загриженост относно
...... Fox News допринесоха за този доклад. Brian Flood е медиен редактор/репортер за FOX News Digital. Съвети за истории могат да се изпращат до и в Twitter: @briansflood.
Кристина Агилера се присъедини от нейния най голям фен зад кулисите
...... уверена в собствената си кожа“, продължи тя. „Отнема време, за да стигнете до това място, но всичко е да прегърнете себе си и тялото си.“
Жена почина след заразяване с H5N6 рядка форма на
...... гади, стомашни болки, болки в гърдите, кървене от носа и венците и конюнктивит. Основните симптоми на птичия грип са: Други ранни симптоми могат да бъдат:
FSA каза Изброените по горе продукти може да са замърсени с
...... да ви разболеят много. Храната, замърсена с тези бактерии, може да доведе до повръщане, диария, коремна болка и в много сериозни случаи изисква медицинско лечение.“
МАРТ 2020 г ДЕРЕК Е ДИАГНОСТИЦИРАН С COVID 19 Съобщава се
...... как облакът се спуска от битката, която му предстои.'Но ако погледнете назад, има известен напредък, сега той има повече думи и гласът му е по-силен."
Звезда от TOWIE беше откарана по спешност в болница във
...... появи в TOWIE на и прекъсване за четири години и също участва в Celebs Go Dating през 2018 г. (видяно в TOWIE с Chloe Sims)
Публикувайки снимка от болничното си легло на канюла в ръката
...... в селото за @vasmorganfoundation възможно най-скоро!“. Той създаде фондацията с цел „борба за по-добро образование в Африка“ и планира да построи училища в Западна Африка.
3 души са починали след заразяване с редки месоядни бактерии в Кънектикът и Ню Йорк
...... за да се понижи вътрешната температура под 50 градуса по Фаренхайт в рамките на три часа след прибиране на реколтата, според държавния Министерство на земеделието.
Мъж в Флорида почина след заразяване с амеба разяждаща мозъка
...... мозъка, известна като първичен амебичен менингоенцефалит – състояние, за което няма известни ефективни лечения. Тя обикновено живее в топли, сладководни езера, реки и горещи извори.
Той се е заразил след като се е измил с
...... мозъка, известна като първичен амебичен менингоенцефалит – състояние, за което няма известни ефективни лечения. Тя обикновено живее в топли, сладководни езера, реки и горещи извори.
Мъж в Флорида почина след заразяване с амеба разяждаща мозъка
...... мозъка, известна като първичен амебичен менингоенцефалит – състояние, за което няма известни ефективни лечения. Тя обикновено живее в топли, сладководни езера, реки и горещи извори.
Антителата не пазят на 100 преболедувал човек от повторно
...... момента са ваксинирани 1, 6 млн. души с AstraZeneca. Едва 13 са получили подобен нежелан ефект. От тях 4 са завършили фатално“, поясни д-р Вълков. Вижте още:
ХИВ не може да се предаде с убождане от игла
...... след рисков сексуален или друг контакт, подчерта тя. За изследването му има бързи тестове, които излизат за 10 минути, правят се с капка кръв от пръста.
11 годишно момиче в Камбоджа почина след заразяване с птичи грип
...... която циркулира и на американския континент. Това доведе до умъртвяването на десетки милиони домашни птици по света, много от които са носители на щама H5N1.
Стрептококовата инфекция тип А погуби осмо дете във Великобритания Баща
...... по-висока от нормалното сред деца на възраст между една и четири години, според данните на Агенцията за здравна сигурност на Обединеното кралство (UKSHA).Превод: GlasNews. bg
Стрептококовата инфекция тип А погуби осмо дете във Великобритания Баща
...... пъти по-висока от нормалното сред деца на възраст между една и четири години, според данните на Агенцията за здравна сигурност на Обединеното кралство (UKSHA).Превод: GlasNews.bg
Франк Моуър най възрастният мъж в Австралия е починал на
...... се е събудил", разказва синът на починалия.Франк Моуър стана най-възрастният австралиец през юли миналата година, след като друг дълголетник, Декстър Крюгер, почина на 111 години.